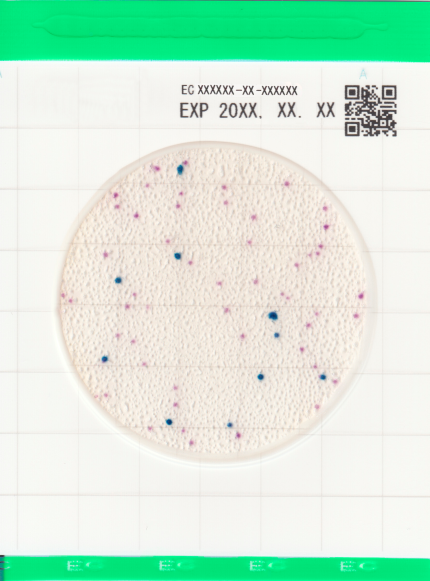
Easy Plate EC

Easy Plate EC
- Simple operation, reliable results
- AOAC PTM certified
- High accuracy
- Ready-to-use, place a sample suspension onto the plate and start incubation
- Very little incubation space and reduced waste
Self-diffusing, Accurate, Certified (AOAC-PTM, NordVal, MicroVal), REDUCES space, time and waste. For E. Coli and Coliforms
Easy Plate EC is a microbiological culture device made up of a waterproof sheet, a readymade dry medium on the sheet and a transparent cover over the medium. The Easy Plate EC method is intended to indicate the level of Escherichia coli and coliform bacteria in selected food products.
It is compact, easy to use, and reduces the total amount of waste produced during testing. The Easy Plate EC method has been granted AOAC Research Institute Performance Tested MethodsSM (031601) for raw beef, raw pork, raw frozen pork, raw lamb, raw salmon, frankfurter sausage and cooked ham.
During the preparation of the plates for incubation, no additional tools are required. This due to the hydrophobic ring around the culture area, which helps with the automatic spreading of the sample on the culture area.
1x 100 plates/pack
Target microorganisms: Escherichia coli and coliform bacteria
Article Number:
61975
Incubation time: 24 hrs
±
1 hrs
Incubation temperature: 35°C
±
1°C
Shelf life: 18 months after manufacturing
Storage: 2-8°C
Prepare the sample according to the manual
Draw up 1 ml of sample solution into a pipette and flip open the cover of the plate. Pipette the sample solution onto the plate and close the cover.
Incubate according to the manual.
https://hyserv.sharepoint.com/:v:/s/Server/EeyU2zJ7ceJJkeQxGoG8NjQBPOcGieK7u9zhmZbmQC-L-g?e=hPABt8
- Easy Plate EC EC20260306A exp 05.09.2027.pdf
- Easy Plate EC EC20260209A exp 08.08.2027.pdf
- Easy Plate EC EC20260109A exp 08.07.2027.pdf
- Easy Plate EC EC20260106A exp 0507.2027.pdf
- Easy Plate EC EC20251114A exp 13.05.2027.pdf
- Easy Plate EC20251014A exp 13.04.2027.pdf
- Easy Plate EC EC20250910A exp 09.03.2027.pdf
- Easy Plate EC EC20250909A exp 08.03.2027.pdf
- Easy Plate EC20250818A exp 17.02.2027.pdf
- Easy Plate EC20250718A exp 17.01.2027.pdf
- Easy Plate EC EC20250610A exp 09.12.2026.pdf
- Easy Plate EC EC20250509A exp 08.11.2026.pdf
- Easy Plate EC EC20250114A exp 13.09.2026.pdf
- 61975_EC20241119A.pdf
- 61975_EC20241118A.pdf
- 61975_EC20241009A.pdf
- 61975_EC20240819A.pdf
- 61975_EC20241004A.pdf
- 61975_EC20240913A.pdf
- Easy Plate EC EC20241009A exp 08.04.2026.pdf
- Easy Plate EC EC20240819A exp 18.02.2026.pdf
- Easy Plate EC EC20240620A exp 19.12.2025.pdf
- Easy Plate EC EC20240711A exp 10.01.2026.pdf
- Easy Plate EC EC20240618A exp 17.12.2025.pdf
- Easy Plate EC EC20240528A exp 27.11.2025.pdf
- 61975_EC20240308A.pdf
- 61975_EC20240410A.pdf
- Easy Plate EC - EC20240410A - exp 09.10.2025.pdf
- Easy Plate EC - EC20240306A - exp 05.09.2025.pdf
- Easy Plate EC - EC20240305A - exp 04.09.2025 .pdf
- Easy Plate EC - EC20240209A - exp 08.08.2025.pdf
- Easy Plate EC - EC20240208A - exp 07.08.2025.pdf
- Easy Plate EC - EC20231218A - exp 17.06.2025.pdf
- Easy Plate EC - EC20231213A - exp 12.06.2025.pdf
- Easy Plate EC - EC20231024A - exp 23.04.2025.pdf